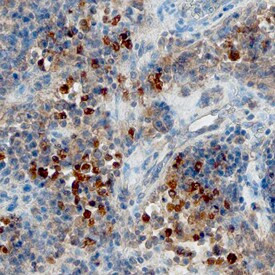
CXCL13 Antibody in Immunohistochemistry (Paraffin) (IHC (P))

Search
Invitrogen
CXCL13 Polyclonal Antibody
{{$productOrderCtrl.translations['antibody.pdp.commerceCard.promotion.promotions']}}
{{$productOrderCtrl.translations['antibody.pdp.commerceCard.promotion.viewpromo']}}
{{$productOrderCtrl.translations['antibody.pdp.commerceCard.promotion.promocode']}}: {{promo.promoCode}} {{promo.promoTitle}} {{promo.promoDescription}}. {{$productOrderCtrl.translations['antibody.pdp.commerceCard.promotion.learnmore']}}
图: 1 / 7
CXCL13 Antibody (PA5-47035) in IHC (P)







产品信息
PA5-47035
种属反应
已发表种属
宿主/亚型
分类
类型
抗原
偶联物
形式
浓度
规格
纯化类型
保存液
内含物
保存条件
运输条件
RRID
产品详细信息
Reconstitute at 0.2 mg/mL in sterile PBS.
Endoxin level is <0.10 EU per 1 µg of the antibody by the LAL method.
靶标信息
CXCL13, also known as BCA-1 and Angie, is a small chemokine strongly expressed in the secondary lymphoid organs. It preferentially promotes the migration of B lymphocytes (both B-1 and B-2) to the follicles of the spleen, lymph nodes, and Peyer's patches. It is produced by macrophages, and in mouse the highest constitutive producers include large peritoneal macrophages, Kuppfer cells and lung macrophages (both CD11c+ and CD11c-). The cellular ligand for CXCL13 is CXCR5 also known as BLR-1 (Burkitt's Lymphoma Receptor 1). CXCR5 is expressed on B cells, Tfh cells and, to a lower degree, some memory T cell populations. CXCL13 plays an important role in the development of chronic lymphocytic leukemia (CCL). CXCL13 is also a plasma biomarker for germinal center activity and generation of broadly neutralizing antibodies against HIV.
仅用于科研。不用于诊断过程。未经明确授权不得转售。
生物信息学
蛋白别名: Angie; B cell-attracting chemokine 1; B lymphocyte chemoattractant; B-cell chemoattractant; B-cell-attracting chemokine 1; B-cell-homing chemokine (ligand for Burkitt's lymphoma receptor-1); B-lymphocyte chemoattractant; BCA-1; C Cmotif chemokine; C X C motif chemokine; C-X-C motif chemokine 13; CC motif chemokine; CCmotif chemokine; chem; chemokine (C-X-C motif) ligand 13 (B-cell chemoattractant); CXC; cxc chemokine; CXC chemokine BLC; CXC motif chemokine; CXC motif chemokine 13; CXCL; CXCL13; small inducible cytokine B subfamily (Cys-X-Cys motif), member 13 (B-cell chemoattractant); Small-inducible cytokine B13
基因别名: ANGIE; ANGIE2; BCA-1; BCA1; BLC; BLR1L; CXCL13; SCYB13
UniProt ID: (Human) O43927
Entrez Gene ID: (Human) 10563